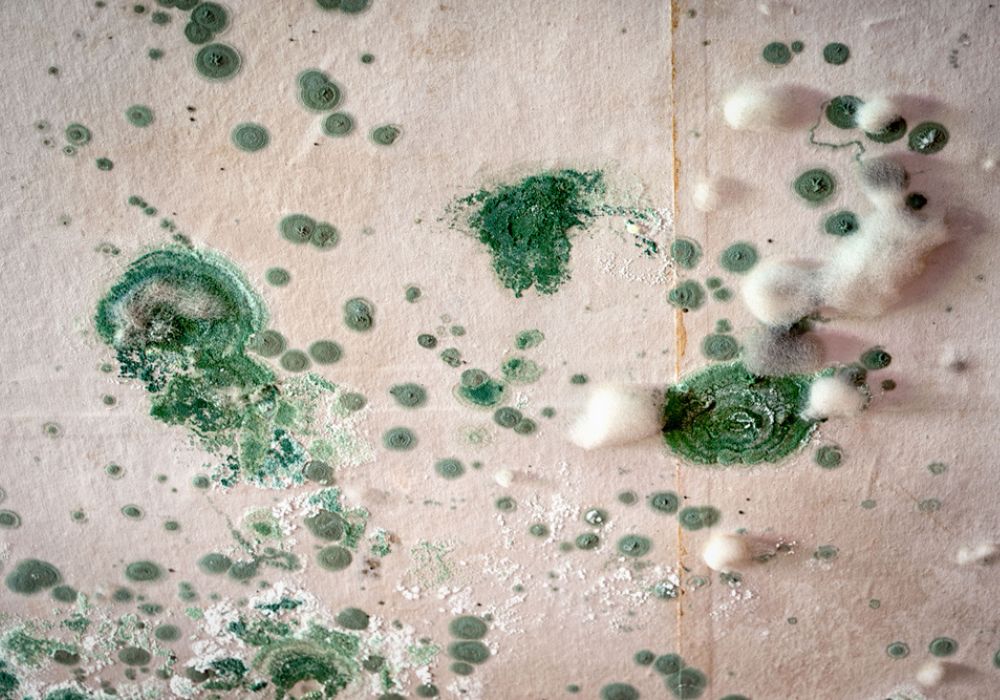

Do you realise that your family’s health is at risk when mould is present in your home? Don’t take chances by living in an environment where hidden mould or airborne mould flourish! Call the mould removal specialists at Crystal Carpet Cleaners Brisbane!
What could be more disgusting or embarrassing than inviting friends over and they find black mould on the seats or other places in your home? It’s not surprising when you consider that mould causes a wide range of health problems that many people are unaware of.
Mould can appear almost anywhere, including couches, sofas, carpets, mattresses, upholstery, and other surfaces. You don’t just want mould gone soon; you want it removed now!
Professional Mould Cleaning Service in Brisbane & Qld Metro Areas
In Brisbane and Queensland, Crystal Carpet Cleaners are the go-to experts when it comes to removing mould.
Our experts offer a micro-bacterial & fungal removal system to sanitise the affected surfaces and treat the cause of mould.
Mould is a problem in many homes and flats, and it has little to do with improper housekeeping.
Why Does Mould Grow on Surfaces?
Mould is commonly caused by a lack of air movement and excessive amounts of moisture. This explains why mould infestation tends to occur in damp places such as bathrooms and laundry rooms.
Hidden mould is also a very common problem, more than most people realise. Mould thrives in dark corners, like skirting boards or in between seat cushions on a sofa. You’ll find it almost anywhere- on carpets, rugs, the floor underneath your carpet, and behind wallpaper!
Many people find that they can promptly remove surface mould with some bleach and water or vinegar, but removing mould is just part of the solution. Mould is stubborn, and even if you succeed in removing it, it will rear its ugly head again and again.
Prevent Mould Growth When You Use Crystal Carpet Cleaners Brisbane
Whenever possible, you can expose the mould-prone area to natural light or use mould-resistant paint. These are easy and practical steps that you can do at home, but what if these two options won’t work for you?
That’s where our expert mould removal service comes in. We will not only remove mould contamination and nearly all mould stains but also remove mould spores from the air.
This is a proactive step to prevent respiratory problems caused by mould. By spraying surfaces with an antimicrobial mist, we can remove nearly all mould spores from the air your family breathes!
Many people find that no repainting is necessary after treatment!
Use Non-Toxic and Eco-Friendly Products
Bleach is commonly used as a mould remediation method, but it is not always safe for all materials. It can also cause respiratory issues for some people.
Bleach can discolour or permanently damage carpet and various types of paint. As we all know, it can ruin your towels and clothing if you aren’t careful.
You could try vinegar since it is more eco-friendly, but again, vinegar is highly acidic and isn’t recommended for many fabrics or surfaces.
It is a common solution but a temporary one since the mould spores are still in your home, just waiting to attach to surfaces again.

Time to Go Green When Removing Mould Growth
Our technicians use cutting-edge technology for mould removal, clean airborne mould spores in the air, and prevent mould from returning.
Never attempt to treat mould on your own because mould is highly toxic. Breathing it can cause all types of allergic reactions and health issues.
Call the experts at Crystal Carpet Cleaners Brisbane today and enjoy a clean, healthier environment tomorrow!
Our Mould Removal & Cleaning Process
For mould removal in Brisbane, you can call our friendly staff for a free quote.
The process starts with our technicians conducting a complete mould inspection of the area(s) where you have seen mould. We will also look for hidden mould that you may not have noticed.

If your situation requires a third-party professional (such as a plumber to repair a leak), we will advise you and recommend a service we trust, or you can call your own repair person.
Our experts will give you a detailed report and an estimate for the services that will be needed to address your mould issue.
The Cleaning Process for Mould Remediation Brisbane QLD
We use insurance-approved dehumidifiers to remove excess moisture and HEPA filters to capture air-borne mould spores in your home.
Our technicians will use a completely natural hot carbonation extraction process to remove all traces and stains of mould.
After any repair issues have been taken care of and the affected areas are completely clean and dry, we apply an anti-mould treatment or mould inhibitor to prevent that disgusting black mould from reappearing.
Don’t just remove mould from the surface!
Crystal Carpet Cleaners Brisbane ensures that mould, even hidden mould, will not return within 12 months, or we will repeat the process at no charge.
Over 10 Years of Local Mould Cleaning in Brisbane
Our family-owned business has lived in the Brisbane area for more than 10 years. We are proud of our expertise in handling the unique issues that homeowners and property managers face when fighting both visible and not-so-visible mould.
Our seasoned team of professionals has stayed up-to-date on the latest methods for removing mould and preventing spores from growing in other places.
Customer Satisfaction Is Our Goal
Our 10-year track record speaks volumes about our commitment to customer satisfaction.
Whether you’re interested in mould removal or a mould prevention treatment, or you are concerned about your home’s indoor air quality due to a recurring mould issue, call the best mould experts in Brisbane.
Affordable Pricing for All Local Brisbane Customers
Removing and avoiding mould exposure is everyone’s goal, but we understand that you don’t want to pay an arm and a leg for it!
Our highly trained technicians are experts at mould removal and mould remediation services at a reasonable price that will have you wondering why you waited so long to call.
Situations vary from household to household, so it’s best to call the friendly staff at Crystal Carpet Cleaners Brisbane for an obligation-free inspection.
Don’t take chances with your health. Prevent serious health issues due to toxic black mould! Call us today!
Areas We Service in Brisbane and Queensland
Whether you live North of the River or South, chances are that we offer mould treatment in your area!
From Kandanga to Ipswich, Fernvale to Harlin, Morayfield to Crossdale, we offer our customers a permanent solution to mould infestation.

Don’t see your area listed? One quick call to the Brisbane mould removal experts will put your mind at ease. Even if you’ve been turned down by other companies, chances are that we service your area! Call our friendly staff today.
Other Cleaning Services We Offer in Brisbane Metro Areas
Mould removal is quite common but not something everyone needs. Crystal Carpet Cleaners Brisbane wants you to know that there is almost no limit to the cleaning services we provide.
Other services include:
- Carpet and rug cleaning
- Upholstery cleaning
- Commercial carpet cleaning
- End of lease/bond cleaning
- Leather cleaning
- Mattress cleaning
- Stain removal
Whatever your residential or commercial cleaning needs are in Brisbane, the expert technicians at Crystal Carpet Cleaners are here to help you live a healthy and mould-free life.
If you don’t see the cleaning job you have in mind listed above, call our expert staff. We are always happy to provide you a free quote and discuss with you your cleaning needs. Call us today!
![]()
A: No, mould removal is not expensive, and every single dollar you pay these professionals is well-spent. Remember that the presence of mould is not only an eyesore – it’s a health risk. The actual cost varies depending on the size of the mould-infested area, the accessibility of the mould, and your property’s location. We need to inspect your property before we can give an estimate, but the average cost to remove and prevent mould is $350 per room. A: If it’s just a small mould, yes, you can. A bleach solution usually works on small areas, say, a section of the shower. When doing this yourself, don’t forget to wear gloves, a face mask, and glasses to protect your skin, face, and eyes. For larger areas, it’s best to consult with a professional mould removal service, such as Crystal Carpet Cleaners Brisbane. A: Yes, there’s still hope even for a mould-infested house. The initial steps include removing the source of moisture and introducing sunlight or moving air. Inspect pipes and roofs for leaks and replace decayed ceilings or other structures. For a major mould treatment and home restoration job like this, it’s best to call the pros.Frequently asked questions
